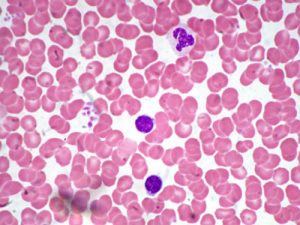

I linfociti T e B
L’insieme dei linfociti T e B può rispondere ad una grande varietà di antigeni. Il meccanismo che spiega come ciò possa avvenire è la teoria della selezione clonale.
Teoria della selezione clonale
Questa teoria afferma che ogni linfocita è programmato nel suo DNA per poter rispondere ad un determinato antigene. Se un linfocita entra in contatto con il proprio antigene inizia a moltiplicarsi e a differenziarsi.
Attraverso delle mitosi si formano quindi moltissimi linfociti identici, che poi producono gli anticorpi specifici. La teoria della selezione clonale spiega poi il fenomeno della memoria immunologica.
Il periodo di latenza di un antigene
Quando un organismo viene a contatto con un antigene per la prima volta, passa un certo periodo di tempo (periodo di latenza) prima che vengano prodotti gli anticorpi. Se successivamente l’organismo incontra di nuovo lo stesso antigene, la sua risposta sarà molto più rapida.
Le cellule della memoria
La teoria della selezione clonale afferma infatti che tra i molti linfociti T e B che vengono prodotti ce ne sono alcuni che vivono molto a lungo (decenni), e che sono già pronti quando l’antigene si ripresenta (risposta secondaria). Questi linfociti sono chiamati cellule della memoria .
Non è stato ancòra spiegato con esattezza quale sia la fonte di una così grande varietà di anticorpi. Essi sono proteine, quindi sono determinate dai geni: le loro sequenza di AA derivano da sequenze di DNA.
Si è notato che i geni che codificano la regione variabile dell’anticorpo (gV), non si trovano vicini a quelli che codificano la regione costante (gC). In più, su una catena di DNA, per ogni gene che codifica una regione costante, ce ne sono molti che codificano l’adiacente regione variabile.
Prima di andare a formare l’mRNA la catena di DNA si apre e solo uno dei tanti gV (a caso) va a sistemarsi vicino al gC. Ciò si ripete ad ogni “giro” di produzione del mRNA. E’ possibile, ma non è sicuro, che i singoli gV siano il risultato di combinazioni di due o più frammenti genici, il che aumenterebbe ancòra di più la varietà di anticorpi prodotti.


